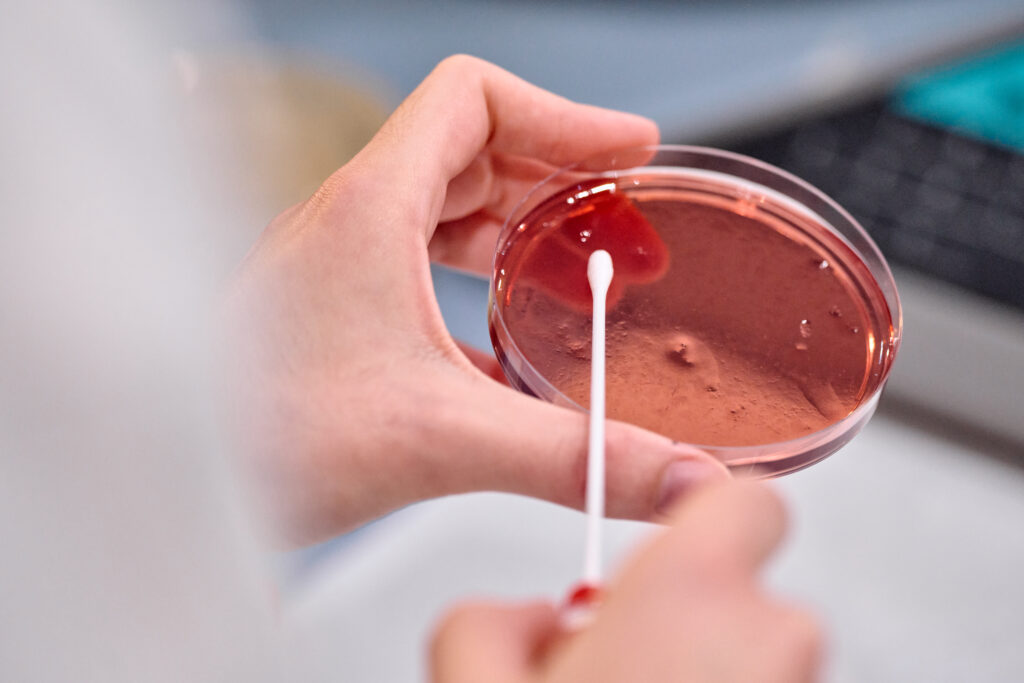

Test de Superficies para la Industria Alimentaria
Para garantizar la seguridad y la calidad en la producción alimentaria, es crucial verificar la eficacia del plan de limpieza e higienización. Nuestro servicio de análisis de superficies evalúa meticulosamente las áreas que entran en contacto con alimentos, como mesas de trabajo, tablas de corte y maquinaria, así como aquellas que, sin contacto directo, pueden ser fuentes de contaminación cruzada, como las ruedas de carros y sumideros.
Inicio / Consultoría
SERVICIOS AVANZADOS DE ANÁLISIS MICROBIOLÓGICO DE SUPERFICIES
Para verificar su plan de limpieza es necesario un control microbiológico de las superficies que entran en contacto con los alimentos: mesas trabajo, tablas de corte, cortadoras de fiambres, maquinaria en general, envases y superficies que aunque no contacten con alimentos pueden suponer un riesgo en la producción de alimentos por una posible contaminación cruzada, como por ejemplo: ruedas de carros, sumideros, etc.
Su objetivo es verificar la higienización de las superficies y correcta aplicación del plan L+D
Los principales tipos de análisis que se realizan en superficies son:
- Determinación de Aerobios mesófilos, Enterobacterias totales, mohos y levaduras, Escherichia coli, Listeria monocytogenes Y Listeria spp
- Detección de Salmonella spp. y Listeria monocytogenes en superficies con esponja abrasiva.
- Detección de Salmonella spp. y Listeria monocytogenes en superficies con esponja abrasiva.
- Test para verificar que las superficies estén libres de alérgenos para controlar la posible contaminación cruzada
Los tests de superficie le permiten conocer si el plan de limpieza es efectivo, evita contaminaciones cruzadas y en consecuencia posibles infecciones.


INNOVACIÓN EN LA DETECCIÓN DE BIOFILMS Y ALÉRGENOS
Tests de Alérgenos: Evaluamos si las superficies están libres de alérgenos, un componente crítico para controlar la contaminación cruzada y garantizar la seguridad del consumidor.
Beneficios de Nuestros Test de Superficie: Los test que realizamos no solo confirman la efectividad de los planes de limpieza y desinfección, sino que también ayudan a prevenir contaminaciones cruzadas y posibles infecciones, asegurando un entorno de producción seguro.

